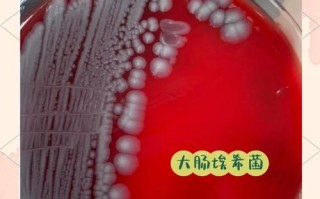
新生儿感染大肠埃希菌肺炎后，如何科学治疗并预防并发症？

如何判断新生儿是否胀气(核心信号)
您可以从宝宝的行为表现和身体特征两方面来综合判断。

行为表现 (宝宝“在做什么”)
-
频繁哭闹,难以安抚:
- 这是最常见的信号,宝宝可能会在固定的时间段(如下午或傍晚)突然开始哭闹,哭声尖锐,听起来很痛苦。
- 即使喂了奶、换了尿布、抱在怀里,也很难让他平静下来。
-
身体紧绷,表情痛苦:
- 哭闹时,宝宝可能会双腿蜷缩至腹部,身体弓起,像一只小虾米。
- 小脸憋得通红,眉头紧锁,表情非常痛苦。
-
吃奶时烦躁不安:
- 在吃奶过程中或吃奶前后,会突然扭动身体、蹬腿、推开乳房或奶瓶。
- 这可能是因为吸吮吞咽时吞入了空气,加剧了腹部不适。
-
睡眠不安稳:
 (图片来源网络,侵删)
(图片来源网络,侵删)- 容易惊醒,睡梦中会突然哭闹或身体抽动。
- 睡眠很浅,稍有动静就可能醒来。
-
放屁多但哭闹不止:
虽然放屁是排出气体的正常方式,但如果宝宝一边放屁一边哭闹,或者放屁后能暂时缓解哭闹,说明这些气体正是造成他不适的元凶。
身体特征 (宝宝“是什么样”)
-
肚子摸起来硬硬的、鼓鼓的:
- 这是最直观的判断方法,在宝宝平静时,轻轻触摸他的小肚子,会感觉比其他部位更硬,像个小皮球。
- 有时能看到腹部微微隆起。
-
拍肚子有“咚咚”的鼓音:
 (图片来源网络,侵删)
(图片来源网络,侵删)用手指轻轻敲击宝宝的腹部,如果发出类似敲鼓的“咚咚”声,说明肠道内积气较多。
-
打嗝、吐奶频繁:
胃里的气需要通过打嗝排出,如果宝宝频繁打嗝或吐奶(非喷射性),也可能是胀气的表现。
新生儿胀气的常见原因
了解了如何判断,我们再来看看为什么会胀气,这有助于从根源上预防。
-
吞入过多空气(最主要原因):
- 吃奶时:无论是母乳喂养还是奶瓶喂养,如果宝宝吸吮过急、含乳姿势不正确,或者奶瓶奶嘴孔过大/过小,都会导致吞入大量空气。
- 哭闹时:宝宝大哭时会大口吸气,也会吞入空气。
- 频繁吞咽口水:3-4个月的宝宝开始流口水,频繁吞咽也可能带入空气。
-
消化系统未发育成熟:
新生儿的消化系统还很娇嫩,消化酶分泌不足,肠道蠕动也不规律,容易产生气体。
-
食物因素:
- 对妈妈饮食敏感(母乳喂养):妈妈如果吃了产气食物(如豆类、洋葱、西兰花、奶制品等),这些成分可能会通过母乳影响宝宝。
- 奶粉不适应(配方奶喂养):部分宝宝可能对所喝的配方奶中的乳糖或蛋白质不耐受,导致产气增多。
- 过早添加辅食:不到4个月的宝宝,消化系统无法处理辅食,容易引起胀气和消化不良。
-
便秘:
大便在肠道内停留时间过长,会被细菌分解产生更多气体,加重胀气。
如何帮助缓解和预防胀气
当宝宝出现胀气时,家长可以尝试以下方法来帮助他:
即时缓解方法
-
拍嗝:
- 喂奶中途:不要等宝宝喝完奶再拍,可以在喂到一半时就暂停,帮他拍个嗝再继续。
- 喂奶后:喂完奶后,一定要竖抱宝宝,让他趴在你的肩膀上,或坐在你的腿上,空心掌由下往上轻轻拍打背部,直到打出嗝为止。
-
腹部按摩:
- 在宝宝清醒、情绪稳定时,以肚脐为中心,用你的手掌心顺时针方向轻轻按摩他的小肚子,这有助于促进肠道蠕动,帮助气体排出,按摩时可以涂抹一些婴儿润肤油,减少摩擦。
-
做排气操:
- 蹬自行车:让宝宝平躺,握住他的两条小腿,像蹬自行车一样交替屈伸。
- 抱腿压腹:让宝宝平躺,轻轻将他的双腿向腹部蜷缩,保持几秒钟再放下,重复几次。
- 飞机抱:让宝宝趴在你的手臂上,头部靠在你的肘窝,腹部贴住你的手臂,轻轻晃动,这个姿势能给宝宝的腹部一定压力,帮助排气。
-
使用飞机枕或排气枕:
- 让宝宝趴着玩(Tummy Time),既能锻炼颈部和背部肌肉,也能利用重力帮助排气。注意:必须在宝宝清醒且有大人看护的情况下进行,防止窒息风险。
-
注意保暖:
腹部受凉也可能导致肠道蠕动减慢,加重胀气,给宝宝穿上肚兜或护肚,注意腹部保暖。
长期预防策略
-
确保正确的喂养姿势:
- 母乳喂养:让宝宝张大嘴,含住大部分乳晕,而不仅仅是乳头。
- 奶瓶喂养:选择防胀气奶瓶和奶嘴,确保奶嘴孔大小适中(奶液应成滴状,而非线状或喷射状),喂奶时让奶瓶倾斜,确保奶嘴始终充满奶液,而不是空气。
-
调整妈妈的饮食(母乳喂养):
- 如果怀疑是妈妈饮食引起,可以尝试暂时避免豆类、奶制品、花椰菜等常见产气食物,观察宝宝症状是否改善。切勿盲目忌口,应保证营养均衡。
-
选择合适的奶粉(配方奶喂养):
如果宝宝对普通奶粉不耐受,可以在医生指导下尝试部分水解蛋白或深度水解蛋白奶粉。
-
避免过度喂养:
按需喂养,但也要注意观察宝宝的饥饿和饱腹信号,避免让他吃得太撑。
⚠️ 何时需要看医生?
虽然新生儿胀气很常见,但如果出现以下“危险信号”,请及时就医:
- 发烧。
- 呕吐呈喷射状,或呕吐物中带血、呈黄绿色。
- 腹泻或便秘情况严重,大便带血。
- 体重增长不理想或下降。
- 精神萎靡,不哭不闹,反应差。
- 腹胀严重且硬如石头,宝宝看起来非常痛苦。
总结一下:判断新生儿胀气,关键在于观察宝宝的行为(哭闹、蹬腿、身体弓起)和身体(肚子硬鼓),通过拍嗝、按摩、排气操等方法可以有效缓解,注意喂养姿势和腹部保暖等预防措施,大部分宝宝的胀气问题会在3-4个月后随着消化系统的成熟而自行缓解,作为父母,您的耐心和安抚就是给宝宝最好的良药。
标签: 新生儿胀气辨别方法 婴儿胀气判断技巧 新生儿胀气应对指南